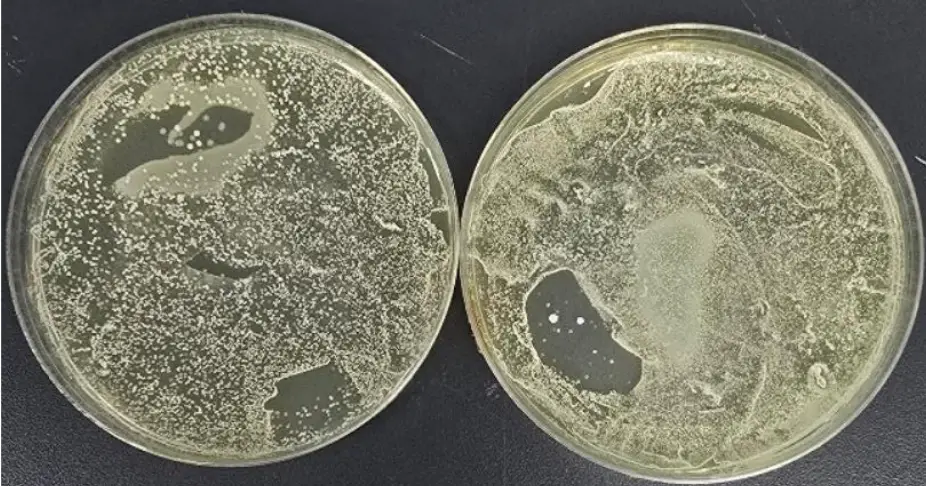
The yeast and mould on the mouthpiece of the vape became 'too numerous to count' in three days (Supplied)

A study has revealed some sickening statistics about how unhygienic vapes can be.
It turns out that the devices are more than 2,000 times dirtier than a toilet seat - so you'd be better off licking the loo than sticking a vape between your lips.
The research, which was conducted by boffins at HAYPP and a leading microbiologist in the UK, might make you think twice about puffing on an e-cigarette.
To put the hygiene of vapes to the test, the team used a refillable pod-style vape, which is made up of a reusable body and detachable mouthpiece.
Advert
Over the course of two weeks, researchers took swabs at various intervals, which were then cultured and analysed for yeast, mould, and specific bacterial species in a lab.
This was done to 'emulate the real-world use of both reusable vapes and pod systems', as they sought to find out 'how residue and bacteria can accumulate' on these devices.
The study found that one particular component of vapes - the mouthpiece - is a prominent 'breeding ground' for bacteria because of its 'warm, moist environment'.

This integral part of the device is a hotspot for germs if they aren't cleaned regularly, researchers say; however, let's be honest, the majority of Brits who vape probably don't prioritise sterilising it after puffing on it all day long.
However, according to Reynold Mpofu, a microbiologist from the testing company BioLabTests, they should. After just three days, the researchers found that the levels of bacteria and fungi on the vape were 2,300 times worse than on a toilet seat.
"Laboratory analysis revealed that the mouthpiece is the dirtiest component of the vape," Mpofu explained.
READ MORE:
MAN WHO VAPED 'EVERY 10 SECONDS' GOT WAKE-UP CALL HE NEEDED AFTER LUNG COLLAPSED
"This isn’t surprising given that the human mouth, largely considered to be one of the ‘dirtiest’ parts of the body, harbours approximately 700 species of bacteria, that amounts to billions of individual bacteria.
"The absence of protective coverings on most vape mouthpieces, coupled with residual heat and moisture provide the optimal conditions for microbial colonisation."
He explained that the mouthpiece also often comes into contact with everyday surfaces, pockets and bags, and therefore picks up a lot of germs.

Concerningly, the study found the presence of everyday skin microbes to more worrying bacteria, such as E. coli, Staphylococcus and Enterococcus.
Yeast and mould growth were also identified on the vapes - and it escalated particularly fast, as the experts said they became 'too numerous to count' for the lab by day three.
The body of the vape wasn't immune to all this gross stuff either, as that also harboured significant bacterial and fungal growth.
Explaining the reason behind why vapes are riddled with bacteria, Mpofu explained that 'germs and dirt from hands, pockets and various environments latch onto the device'.
READ MORE:
HERE ARE THE LONG-TERM EFFECTS OF VAPING AS USERS SURPASS SMOKERS IN NUMBERS
He suggested a likely explanation for this is 'inadequate hand hygiene or the transfer of microorganisms from bathroom environments or other contaminated surfaces'.
"Paired with routine contact with faces, mouths, toilets, door handles, other people, and even floors, this provides the perfect opportunity for microbes to transfer to the vape," Mpofu said.
According to the microbiologist, the study highlights the 'critical importance of regular cleaning and exceptional hygiene' when using a vape.
"Every touch, surface and puff adds up, and maintaining a clean mouthpiece and device is not just about aesthetics, it’s a matter of health and hygiene," he added.
Markus Lindblad, Head of Legal and External Affairs at HAYPP, also urged people to 'learn good vape hygiene' for the sake of their health.
He explained: "Our study shows just how quickly bacteria can build up on a vape - even forming sticky, biofilm-like layers that aren’t easy to remove with a quick wipe on your sleeve, for example.
"This is particularly important for the newer non-disposable models, as well as existing devices that are used over more extended periods and can remain contaminated if not cleaned regularly.
"Just as we wash our hands when we get home, it’s a good idea to give your vape a similar once-over, depending on how frequently it’s used."
Lindblad recommends 'wiping down' both the mouthpiece and the body of the vape every three days using a 'cloth dampened in antibacterial cleaner or an alcohol wipe'.
"Most advice online recommends once a week; however, our research shows this is far too long between cleans," he said.
"For vapes with interchangeable pieces, these should be removed and cleaned individually to ensure no bacteria or residue is left behind."